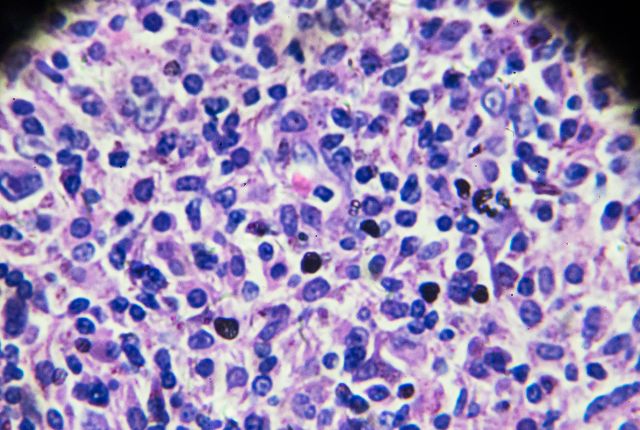
Lymphome non hodgkinien : définition et taux de guérison. Cellules d'un lymphome non hodgkinien vues au microscope.

Les lymphomes non hodgkiniens sont des cancers dans lesquels les globules blancs sont touchés, entraînant possiblement la dissémination de cellules cancéreuses dans l'organisme. Il existe deux formes : une dite indolente qui peut évoluer très lentement durant des années et une autre, dite agressive, qu'il faut traiter le plus tôt possible.
Définition : qu’est-ce qu’un lymphome non hodgkinien ?
Le lymphome non hodgkinien est un cancer du système immunitaire. Il débute à partir des globules blancs appelés lymphocytes B et, moins souvent lymphocytes T. Ces globules blancs jouent un rôle essentiel dans l'immunité et la défense de l'organisme contre les germes. Les cellules cancéreuses peuvent atteindre toutes les parties du corps en circulant dans les vaisseaux (du sang ou de la lymphe). Ce lymphome rentre dans la catégorie plus large des cancers du sang.
Cancer du sang
Les organes les plus touchés sont généralement :
-
amygdales;
-
rate;
-
moelle osseuse;
-
tube digestif;
-
peau...
Il existe plusieurs formes de lymphome non hodgkinien et leur prise en charge dépend des symptômes, de l'évolution de la maladie et de la réponse aux traitements.
Quelle est la différence entre un lymphome hodgkinien et non hodgkinien ?
Les lymphomes non hodgkinien (LNH) sont de loin les plus fréquents. En outre, le lymphome de Hodgkin (LH) se caractérisent par la présence d'un type de cellule en particulier : les cellules de Reed-Sternberg qui sont des formes de lymphocytes B anormales.
Lymphome ou maladie de Hodgkin ou hodgkinien (LH)
Un peu plus de 2000 personnes sont touchées tous les ans par le lymphome hodgkinien. Il concerne généralement de jeunes adultes (parfois aussi des personnes âgées). C'est un cancer qui répond bien aux traitements et dont le taux de guérison atteint en moyenne plus de 80% à 10 ans, précise la Ligue contre le cancer (données 2018).
Lymphome non hodgkinien (LNH)
Le lymphome non hodgkinien touche plus de patients et patientes : soit environ 22000 personnes par an. Il représente 90% de l'ensemble des lymphomes diagnostiqués tous les ans dans notre pays.
Quels sont les premiers symptômes d'un lymphome non hodgkinien ?
Les symptômes dépendent de la localisation de la maladie dans l'organisme. Le premier signe est souvent un gonflement des ganglions. Ils peuvent aussi s'accompagner de. :
-
gonflement de la face et du cou;
-
toux sèche et persistante si les ganglions thoraciques sont touchés;
-
jambes lourdes et gonflées si les ganglions de l'aine sont touchés;
-
gènes et douleurs abdominales si les ganglions situés dans l'abdomen sont touchés;
Des symptômes non spécifiques sont décrits :
-
fièvre qui ne passe pas;
-
sueurs souvent la nuit;
-
peau qui gratte;
-
fatigue;
-
perte de poids inexpliquée...
Ces signes doivent mener une personne à consulter son ou sa médecin traitant, n'hésitez pas à contacter une ou un généraliste. Ils ne suffisent pas à caractériser la présence d'un lymphome non hodgkinien. Des analyses doivent être menées.
Diagnostic du lymphome non hodgkinien
Le ou la praticienne cherchera la présence de ganglions. Ils sont souvent gonflés, non douloureux et sans rougeur et généralement situés au niveau du cou ou des aisselles (sous les bras). S'il n'y a pas d'autres causes expliquant ce phénomène (infection, abcès dentaire...), il ou elle adressera le ou patiente vers un ou une spécialiste en hématologie pour notamment réaliser des examens sanguins.
Ceux-ci peuvent mettre en évidence la présence de lymphocytes anormaux et leur diffusion. La biopsie permet de confirmer ou infirmer le diagnostic. Elle peut se dérouler en étant guidée par échographie ou scanner à l'hôpital. Le ganglion peut être retiré en entier (biopsie exérèse). L'analyse anatomopathologique qui suit précise le caractère malin des cellules et le type de lymphome en cours.
Cette phase de diagnostic est suivie par un bilan de localisation et d'extension afin de vérifier l'étendue du cancer. Elle fait appel à ces techniques d'imagerie :
-
radiographie thoracique;
-
scanner;
-
échographie du cou-thorax-abdomen-pelvis;
-
échographie de l'abdomen et du bassin;
-
IRM;
-
TEP.
D'autres examens peuvent être pratiqués :
-
endoscopie;
-
myélogramme de la moelle osseuse;
-
analyse du liquide céphalorachidien (ponction lombaire).
Tous ces examens permettent de comprendre l'extension du cancer, s'agissant d'une pathologie qui peut prendre différentes formes pour chaque patiente ou patient, et de proposer les traitements appropriés.
Comment évolue un lymphome non hodgkinien ?
Les spécialistes distinguent souvent deux formes de lymphome non hodgkinien et l'évolution du LNH dépend du sous-type qui se manifeste :
-
lymphome dit indolent : il évolue lentement, mais, en revanche, il répond aussi lentement aux traitements. 40 à 50 % des malades atteints de LNH sont concernés. Le cancer peut se développer sur plusieurs années précisent les autorités sanitaires.
-
lymphome dit agressif : il est évolutif rapidement, mais il répond souvent très bien à la chimiothérapie. Il est considéré souvent comme curable. Ce type de lymphome concerne entre 50 et 60% des malades atteints de LNH. La prise en charge doit se faire rapidement. Cela concerne souvent les enfants atteints de lymphomes non hodgkiniens.
Causes d’un lymphome non hodgkinien ?
Les spécialistes ignorent encore les causes de ce cancer. Plusieurs facteurs seraient impliqués comme :
-
infection chronique virale ou bactérienne : hépatite C, VIH, virus d'Eptein-Barr, helicobacter pylori.
-
déficit immunitaire et traitement immno-suppresseur;
-
maladie cœliaque;
-
exposition à des pesticides, solvants organiques, poussières de bois...
Est-il possible de guérir d'un lymphome non hodgkinien ?
La Fondation pour la recherche sur le cancer souligne les progrès thérapeutiques réalisés depuis ces 2O dernières années et ajoute que la moitié des lymphomes dits agressifs peuvent être guéris. En effet, la stratégie de traitement diffère selon le type de lymphome.
Les personnes atteintes d'un lymphome dit indolent n'ont pas toujours besoin d'un traitement s'il n'y a pas de symptômes et s'il n'est pas ou peu étendu, mais doivent bénéficier d'un suivi car le lymphome peut devenir agressif. Les patients ou patientes atteintes d'un lymphome dit agressif doivent recevoir un traitement rapidement, souvent une combinaison de chimiothérapie et immunothérapie.
Parmi les traitements se trouve :
-
la chimiothérapie
-
l'immunothérapie (thérapie ciblée par anticorps monoclonaux);
-
la radiothérapie;
-
la greffe de cellules souches.
Les spécialistes notent des effets secondaires, notamment des risques infectieux.
Quelle espérance de vie avec un lymphome non hodgkinien ?
Le taux de guérison dépend de plusieurs facteurs. Plus ceux-ci sont présents, plus les chances de guérison baissent. Sans ces facteurs, les taux de guérison sont, selon les sources, d'environ 60-70%. 80% si l'on compte les personnes pour lesquelles le traitement répond, sans atteindre la guérison. L'âge (plus de 60 ans), un stade III ou IV de la maladie, notamment, assombrissent le pronostic. Il existe des risques de rechutes souvent traitées par la greffe de cellules souches. Ces éléments restent statistiques et peuvent se révéler éloignés de la réalité au jour le jour des patients et patientes.
Est-ce qu'un lymphome non hodgkinien est mortel ?
Le lymphome non hodgkinien est de mieux en mieux pris en charge, mais il existe des cas où la maladie a évolué, où la santé du ou de la patiente est fragile et où les traitements ne répondent pas et peuvent entraîner des effets secondaires lourds. Sans oublier les risques de rechute. Ce cancer peut malheureusement être mortel.
Cet article médical a été écrit par un rédacteur expert santé et SEO (EEAT et YMYL), Pierre Luton, et relu et validé par un médecin spécialiste en oncologie au sein d’un établissement ELSAN, groupe leader de l’hospitalisation privée en France. Il a un but uniquement informatif et ne se substitue en aucun cas à l’avis de votre médecin, seul habilité à poser un diagnostic.
Pour établir un diagnostic médical précis et correspondant à votre cas personnel ou en savoir davantage et avoir plus d’informations sur votre pathologie, nous vous rappelons qu’il est indispensable de prendre contact et de consulter un médecin.
Contactez les praticiens oncologues médicaux au sein des hôpitaux privés ELSAN, qui vous reçoivent en RDV près de chez vous, dans l’un de nos établissements.
Vos questions fréquemment posées sur le lymphome non hodgkinien et les lymphomes :
Un lymphome est une pathologie cancéreuse qui touche le système lymphatique qui joue un rôle déterminant dans l'immunité. Il se compose de vaisseaux lymphatiques, de ganglions collecteurs. Ses organes sont le thymus, la moelle osseuse, la rate, les amygdales, l'appendice et les plaques de Peyer. En somme, il s'agit d'un cancer du système immunitaire.
En moyenne, le taux de guérison attendu est d'environ 70%. Il dépend de beaucoup de facteurs : âge, état de santé, type de lymphome, réponse aux traitements. A savoir que les lymphomes non hodgkiniens indolents peuvent se développer lentement sur plusieurs années et que les traitements ne sont pas toujours nécessaires dans ce cas. Un suivi, en revanche, est indispensable.
Certains lymphomes nécessitent un suivi mais pas toujours de traitement. Quand un traitement est nécessaire, il s'agit souvent d'une chimio-immunothérapie. La greffe de cellules souches intervient souvent en cas de rechute.
Selon le centre Léon-Bérard, le lymphome T à forme extra-ganglionnaire (lymphome hépato-splénique ou lymphome T/NK de type nasal) est celui qui présente le plus d'agressivité et est réputé pour être souvent résistant aux traitements. Ces données médicales ne reflètent pas toujours le vécu des patients et patientes.
Pathologies associées à l'Oncologie/Cancérologie
Nos oncologues / cancérologues à proximité

Oncologie médicale
Découvrez tout ce que vous devez savoir sur l'Oncologie Médicale chez ELSAN








